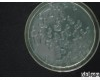
灰葡萄孢（<em>灰霉病</em>菌）品Pai

木霉菌杀菌剂 木霉菌杀菌剂FZ灰霉病药灰霉病如何FZ木霉菌生物农药
- 型号:木霉菌杀菌剂
- 产地:广州市
- 供应商:广州市微元生物科技有限公司
- 供应商报价:面议
- 标签:木霉菌杀菌剂防治灰霉病特效药灰霉病如何防治木霉菌生物农药,80,广州市微元生物科技有限公司
木霉菌杀菌剂FZ灰霉病药灰霉病如何FZ木霉菌生物农药
微元-复合木霉菌
137 2529 3680(庞) 135 8040 6804(钟) 180 1198 5576(潘)
【菌种成分】复合菌 【菌种状态】粉剂
【菌溶解性】半可溶 【菌种含量】有效活菌数≥2×1010cfu/g
【适用范围】
有效针对农作物植物、花卉、果树的根腐病、立枯病、猝倒病、枯萎病等土传病害、灰霉菌、腐霉菌、丝核菌、炭疽菌、镰刀菌、菌核病。

【产品概述】
微元-复合木霉菌是新型生物农药。通过产生抗生素、营养竞争、微寄生、细胞壁分解酵素、以及诱导植物产生抗性等机制,对于多种植物病原菌具有拮抗作用,复合木霉菌具有保护和ZL双重功效,可有效FZ土传性真菌病害,在苗床使用木霉菌剂,可提高育苗与移植的成活率,保持秧苗健壮生长。也可用于FZ灰霉病;期长,作用位点多,不产生抗药性,突破常规杀菌剂受限条件,不怕高湿,而且湿度越大FZ效果越好。杀菌谱广,无残留毒性,对作物没有任何不良影响。
【作用机理】
1、拮抗作用:木霉菌通过产生小分子的抗生素和大分子的KJ蛋白或胞壁降解酶类来YZ病原菌的生长、繁殖和侵染。木霉菌在抗生和菌寄生中,可产生几丁质酶、β21,3葡聚糖酶、纤维素酶和蛋白酶来分解植物病原真菌的细胞壁或分泌葡萄糖苷酶等胞外酶来降解病原菌产生的抗生毒素。同时,木霉菌还分泌KJ蛋白或裂解酶来YZ植物病原真菌的侵染。
2、竞争作用:木霉菌可以通过快速生长和繁殖而夺取水分和养分、占有空间、消耗氧气等,以至削弱和排除同一生境中的灰霉病病原物。
3、重寄生作用:研究发现木霉菌会在特定环境里形成腐霉对灰霉病菌具有重寄生作用,它进入寄主菌丝后形成大量的分枝和有性结构,因而能YZ葡萄灰霉病症状的出现。
4、诱导抗性:木霉菌可以诱导寄主植物产生防御反应,不仅能直接YZ灰葡萄孢的生长和繁殖,而且能诱导作物产生自我防御系统获得抗病性。
5、促生作用:经研究表明,木霉菌在使用过程中,不仅能控制灰霉病的发生,而且能增加种子的萌发率、根和苗的长度以及植株的活力。
【产品功效】
1.FZ土传病害:针对土壤传播性土传病害所筛选的木霉菌菌株,以天然基质发酵生产。并以超寄生与抗生方式破坏并分解病原菌菌体,同时可促进植株根部生长。适合与有机肥混拌增殖后使用,也可以育苗期开始使用,效果更为显著。
2.使用范围广:木霉菌对多种植物病原真菌有拮抗作用,FZ范围广泛。腐生性强,一药多用,降低FZ成本,寄生的同时可产生各种抗生素和溶解酶,降低病原的抗药性,加强YJ强度;木霉菌的几丁质酶基因可在细菌、真菌和植物中表达,可FZ植物真菌病害、促进农作物生长。
【用法用量】
复合木霉菌依不同作物种类与作物不同时期有不同的使用方式,主要是要让木霉菌均匀分布于植物根部、表面与土壤中,短期作物使用1-2次,果树花卉等多年生作物每年使用3-4次即可,使用次数越多效果越明显,长期使用可有效减少土壤传播性土传病害发生,多用有益无害。木霉菌使用时可添加适量米糠或豆粕以增加田间木霉菌增殖的能量及方便复合木霉菌在田间的分散性,使用量约为木霉菌之20-40倍。
1、灌根、喷雾:每公斤复合木霉菌兑水100L以上培菌扩繁;扩繁时每公斤复合木霉菌添加250-500克红糖进行辅助培菌;Z佳扩繁水温为25-30℃,扩繁培菌4-8小时。扩繁后兑水稀释300-500倍进行灌根,喷雾施用。
2、处理土壤:将复合木霉菌剂和育苗基质以1公斤稀释300-500倍的比例充分混合后直接播种或扦插。若直接处理苗床,可按1公斤稀释10倍的比例与育苗基质混匀后,撒入苗床;每公斤处理苗床10-15平方米。
3、拌种或浸种:将每公斤复合木霉菌剂稀释100倍,浸种2小时后播种,或者播种前每公斤种子用10-20克菌粉拌种后直播。
4、根部处理:移栽前,复合木霉菌剂1公斤稀释100倍液浸根30分钟,然后定值;移栽后,可用300-500倍液灌根。
5、制作生物肥:每吨有机肥中可添加1.5-2公斤的复合木霉菌剂或可以直接混到农作物废弃物粉末(米糠,锯末,草粉等接种)可用作为生物肥料使用。
备注:预防真菌性土传病害建议用量:300-500g/亩,ZL用量:800-1000g/亩。
【注意事项】
(1)本产品不能与农药及杀菌剂同时灌根施用;
(2)施用本产品需要保持土壤湿润,以免土壤干燥而影响微生物的作用;
(3)本产品应存放在阴凉干燥处,避免阳光直射,开封后未用完的产品应及时扎口密封储存;
(4)开封后储存过程中如有异味,属于部分微生物菌被激活发酵所致,不影响效果。
注:本司仅对本产品质量负责,因其它因素造成的不当结果,概不负责。
【包装容量】1kg/包;25kg/袋
【保存期限】12个月
【保存方法】请密封放置干燥阴凉避光处
【生产日期】见封口或打码处
【生产公司】广州市微元生物科技有限公司
【企业】http://www.gzwybio。。com
【阿里】http://www.gzwybio。。net
【阿里旺铺】http://gzwybio.
【淘宝店铺】http://gzwybio.taobao.com
【公司地址】广州市黄浦区科学城科学大道中101号科汇金谷K栋506
【技术咨询】: :510670